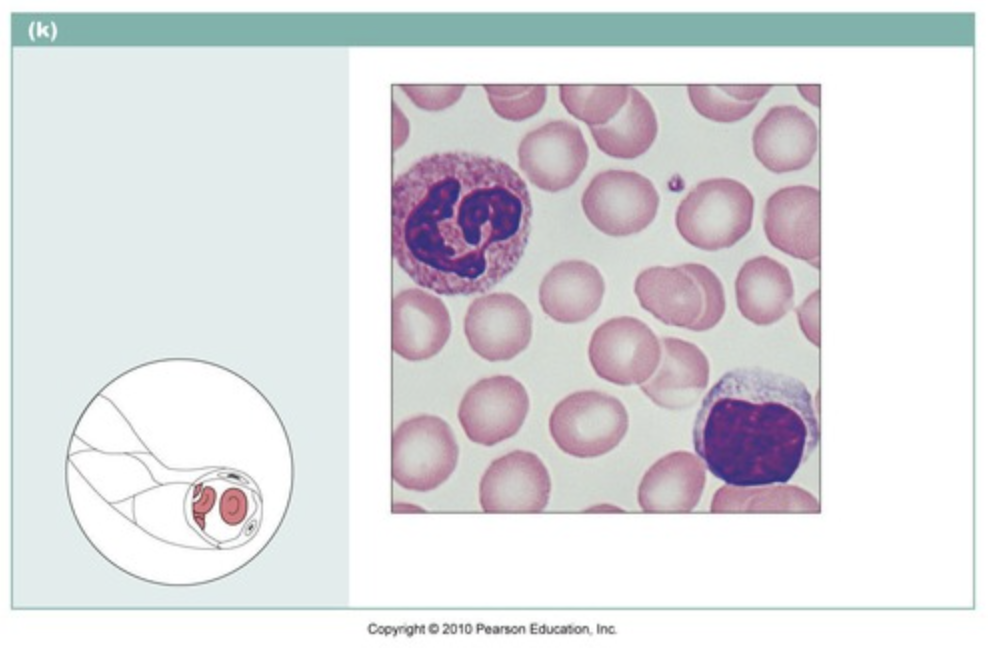

name the type of epithelial tissue

simple squamous
name the type of epithelial tissue

simple cuboidal
name the type of epithelial tissue

simple columnar
name the type of epithelial tissue

stratified squamous
describe the function of the simple columnar epithelial

- absorption & secretion of mucus, enzymes, & other substances
- line the digestive tract
describe the function of stratified squmous epithelial

- protects underlying tissues in areas subject to abrasion
- ex: outer layer of skin & inside of mouth & esophagus
describe the function of loose connective tissue (areolar)
- holds epithelial tissue to another tissue
name the type of connective tissue

loose connective tissue, adipose (fat)
name the type of connective tissue

loose connective tissue, reticular
name the type of connective tissue

dense connective tissue, regular
name the type of connective tissue

dense connective tissue, elastic
name the type of connective tissue

cartilage
name the type of connective tissue

osseous tissue, bone
name the type of connective tissue
blood
name the type of tissue

nervous tissue
name the type of muscle tissue

skeletal muscle
name the type of muscle tissue

cardiac muscle
name the type of muscle tissue

smooth muscle
which muscle tissue is multinucleate?
(has multiple nuclei)
skeletal
which muscle tissue has intercalated disks (spaces) between cells?
cardiac
what type of epithelial tissue provides protection with many layers of flattened cells?
stratified squamous
what type of epithelial tissue lines the air sacs of lungs & the blood vessels, & is one layer & very thin?
simple squamous
what type of epithelial tissue is usually associated with absorption & secretion?
simple cuboidal & simple columnar
what is the most abundant tissue type in the body?
connective


